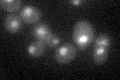
YAR003W
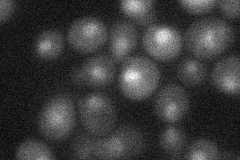
YAR003W
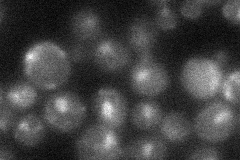
YAR003W
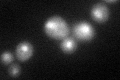
YAR003W

View description
Subunit of the COMPASS (Set1C) complex, which methylates histone H3 on lysine 4 and is required in transcriptional silencing near telomeres; WD40 beta propeller superfamily member with similarity to mammalian Rbbp7
Localization:
Intensity:
Fold change:
Significance:
-
C’ GFP library in SD
nucleus22.96 -
N' NOP1pr-GFP in SD

nucleus42.1038 -
N' TEF2pr-mCherry in SD
nucleus14.9636 -
N' NATIVEpr-GFP in SD
nucleus21.5631 -
N' TEF2pr-VC and Cyto-VN in SD

#N/A0 -
C’ GFP library in SD+DTT
nucleus29.261.27No -
C’ GFP library in SD+H2O2

nucleus23.951.04No -
C’ GFP library in Starvation Media

nucleus17.970.78Yes -
C’ GFP library on the background of Pup2-DaMP

nucleus -
C’ GFP library on the background of CCT mutant

nucleus20.37880.887151No
